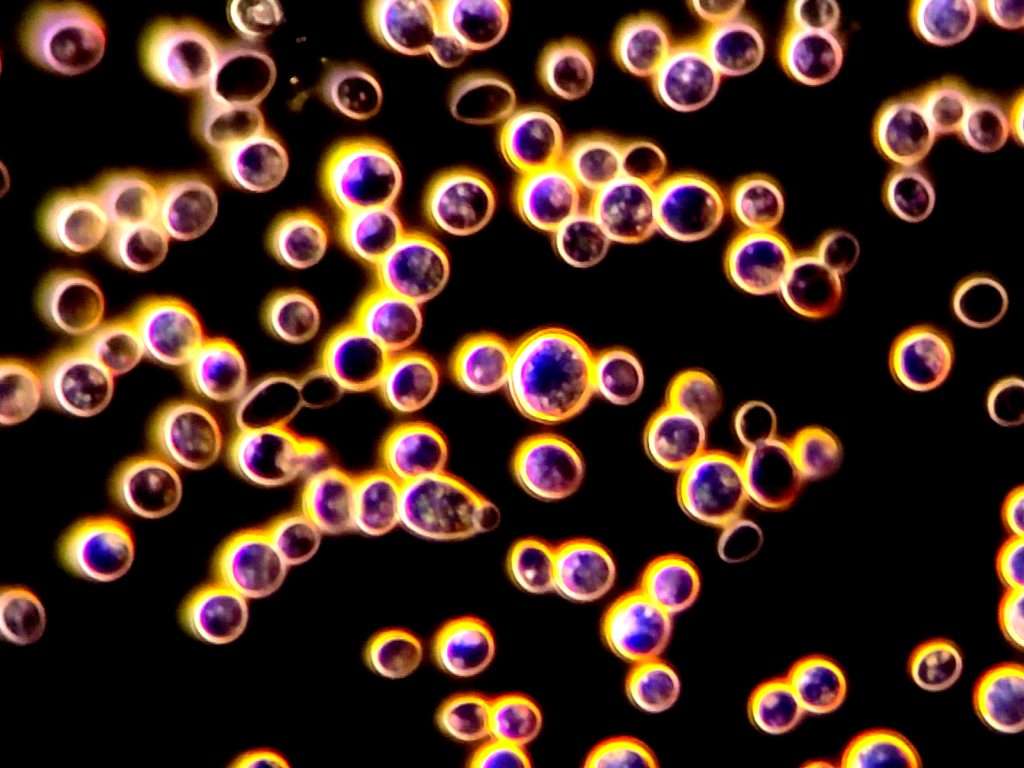

Delivering results, one microbe at a time.
Explore Proxima’s specialized services across industries like brewing and winemaking, biofuels, life sciences, pharmaceuticals, and agriculture.
We deliver customized fermentation analytics, microbial strain development and optimization, protein reagents, vector construction, and custom assays to support your research and development needs.
Solutions For Your Industry
OUR SERVICES
At Proxima, we specialize in delivering innovative and cost-effective solutions tailored to meet your business goals.
We’re here to help! Let’s discuss your goals and how we can help you achieve them.
Fermentation & Microbiology
Proxima offers cost-sensitive scientific services including strain screening, fermentation analysis, and custom strain creation using advanced techniques like CRISPR. These solutions guide small to large producers in optimizing fermentation processes.
Vector Construction & Archiving
Proxima provides secure DNA vector archiving, NGS sequencing, and vector construction services, ensuring accuracy and ease of access for researchers.
Proteins
Specializing in protein expression and purification from a wide variety of platforms, Proxima offers customized proteins with various conjugations, producing them more affordably than commercial alternatives.
Reagents
Proxima produces both common and custom reagents, ensuring quality and confidentiality at competitive rates.
Microbiome Profiling & Metagenomics
Proxima offers the most affordable and accurate microbiome profiling in Canada, with industry leading turnaround and easy-to-understand reporting. Handling diverse sample types with ease and efficiency, Proxima offers customized solutions from basic metabarcoding to deep metagenomic sequencing and bioinformatic analysis.
Contract Research
Proxima designs and implements assays, isolates biomolecules, and offers customized research solutions for biotechnology projects across various industries. We also excel at affordable genomic sequencing, from bacteria and fungi through to plants and animals, including all steps from DNA extraction to genome assembly and annotation.
